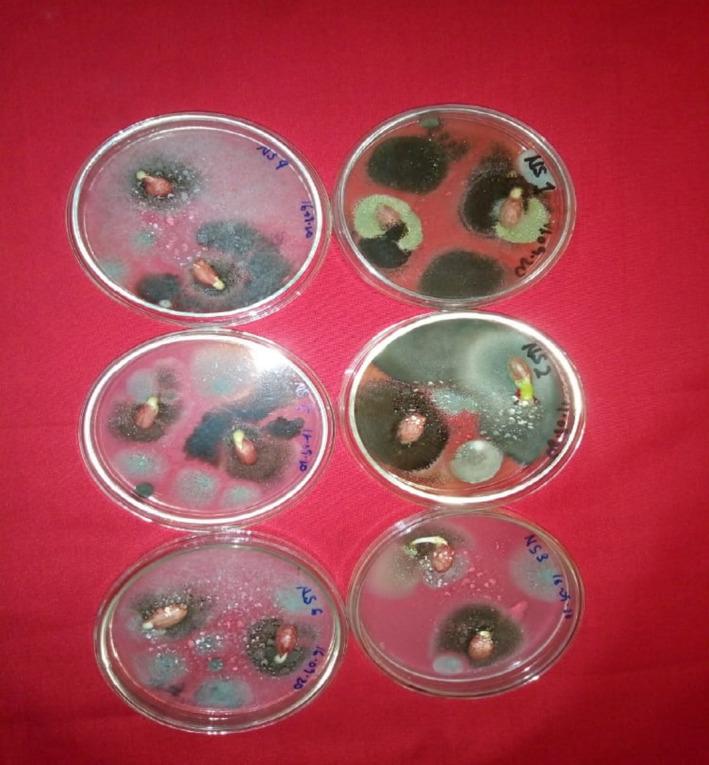
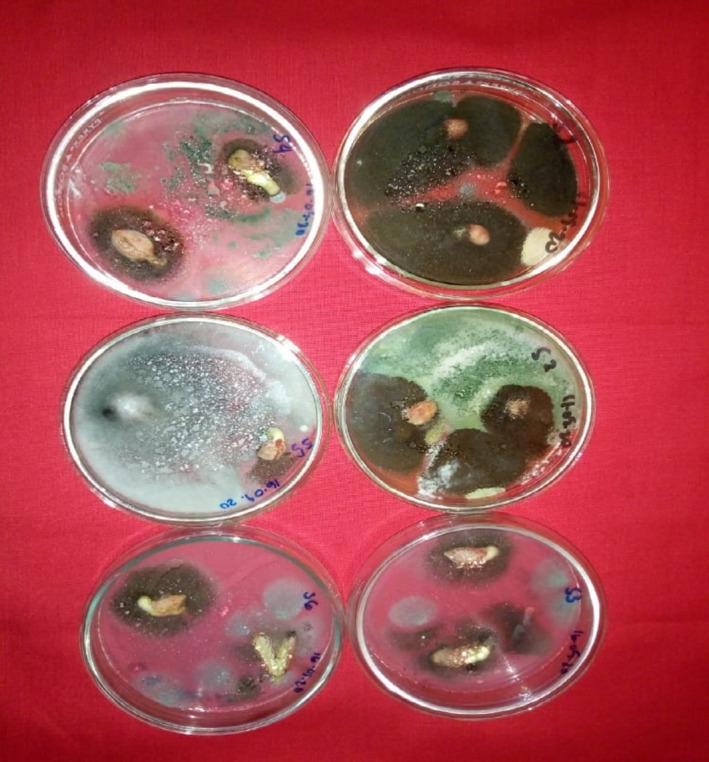

与加纳沃尔特地区储存的落花生(L.)相关的真菌群落概况、物候学以及潜在的产毒和致病物种。
Mycobiota profile, phenology, and potential toxicogenic and pathogenic species associated with stored groundnuts ( L.) from the Volta Region, Ghana.
作者信息
Kortei Nii Korley, Tetteh Rachel Adinorkie, Wiafe-Kwagyan Michael, Amon Denick Nii Kotey, Odamtten George Tawia
机构信息
Department of Nutrition and Dietetics School of Allied Health Sciences University of Health and Allied Sciences Ho Ghana.
Department of Plant and Environmental Biology College of Basic and Applied Sciences University of Ghana Legon Ghana.
出版信息
Food Sci Nutr. 2022 Jan 10;10(3):888-902. doi: 10.1002/fsn3.2719. eCollection 2022 Mar.
This study updates the mycobiota resident in groundnut seeds, their phenology during storage with the view to ascertain their occurrence, potential toxigenic species, and pathologically important species in the stored samples. The moisture content of the seeds ranged from 5.7% to 6.5% within the stipulated safe moisture content of 8% for extension of shelf life. Culturing the seeds on mycological media (Sabouraud's Dextrose Agar SDA; Oxytetracycline Glucose Yeast Extract OGYE, Potato Dextrose Agar, PDA) caused a de novo growth of the quiescent spores at 28-30°C for 7-14 days. Fungal population counts on the three media ranged from 2.01 to 2.16 log CFU/g samples to a final 6-month count of 1.67-2.60 log CFU/g. Eighteen different fungal species belonging to ten genera were encountered on the media, namely , and . . (, and were the most frequently isolated, followed by , and and and , and . The species which were seed borne , and were isolated on both surface sterilized and non-surface sterilized seeds. The phenology of the encountered fungal species generally followed five patterns. The most frequently isolated , and predominated throughout the 6 months sampling period, while and appeared sporadically and disappeared. The early colonizers (, and ) could not be isolated after 2-3 months owing presumably to stronger antibiosis competition from the species. The most predominant species initially constituted 36%-48% of the total population but declined to 10%-36% in 6 months. Mycobiota encountered with mycotoxigenic potential and human health importance were , and . Other species of pathological importance to plants were and . The practical implications of these findings are discussed.
本研究更新了花生种子中的真菌群落及其储存期间的物候情况,旨在确定储存样品中真菌的存在情况、潜在产毒物种和具有病理学重要性的物种。种子的水分含量在规定的8%安全水分含量范围内,为5.7%至6.5%,以延长保质期。将种子接种在真菌培养基(沙氏葡萄糖琼脂培养基SDA;土霉素葡萄糖酵母提取物培养基OGYE、马铃薯葡萄糖琼脂培养基PDA)上,在28 - 30°C下培养7 - 14天,使静止孢子重新生长。在这三种培养基上的真菌种群计数范围为2.01至2.16 log CFU/g样品,到6个月后的最终计数为1.67 - 2.60 log CFU/g。在培养基上共发现了属于10个属的18种不同真菌,即 , , , , , , , , , 。 , , 是最常分离到的,其次是 , , , , 。种子携带的物种 , , 在表面灭菌和未表面灭菌的种子上均被分离到。所遇到的真菌物种的物候情况一般遵循五种模式。最常分离到的 , , 在整个6个月的采样期内占主导地位,而 , 偶尔出现并消失。早期定殖者( , , )在2 - 3个月后无法分离到,可能是由于 物种更强的抗生竞争。最主要的 物种最初占总种群的36% - 48%,但在6个月内降至10% - 36%。具有产毒潜力和对人类健康有重要意义的真菌群落包括 , , 。对植物具有病理学重要性的其他物种是 , 。讨论了这些发现的实际意义。